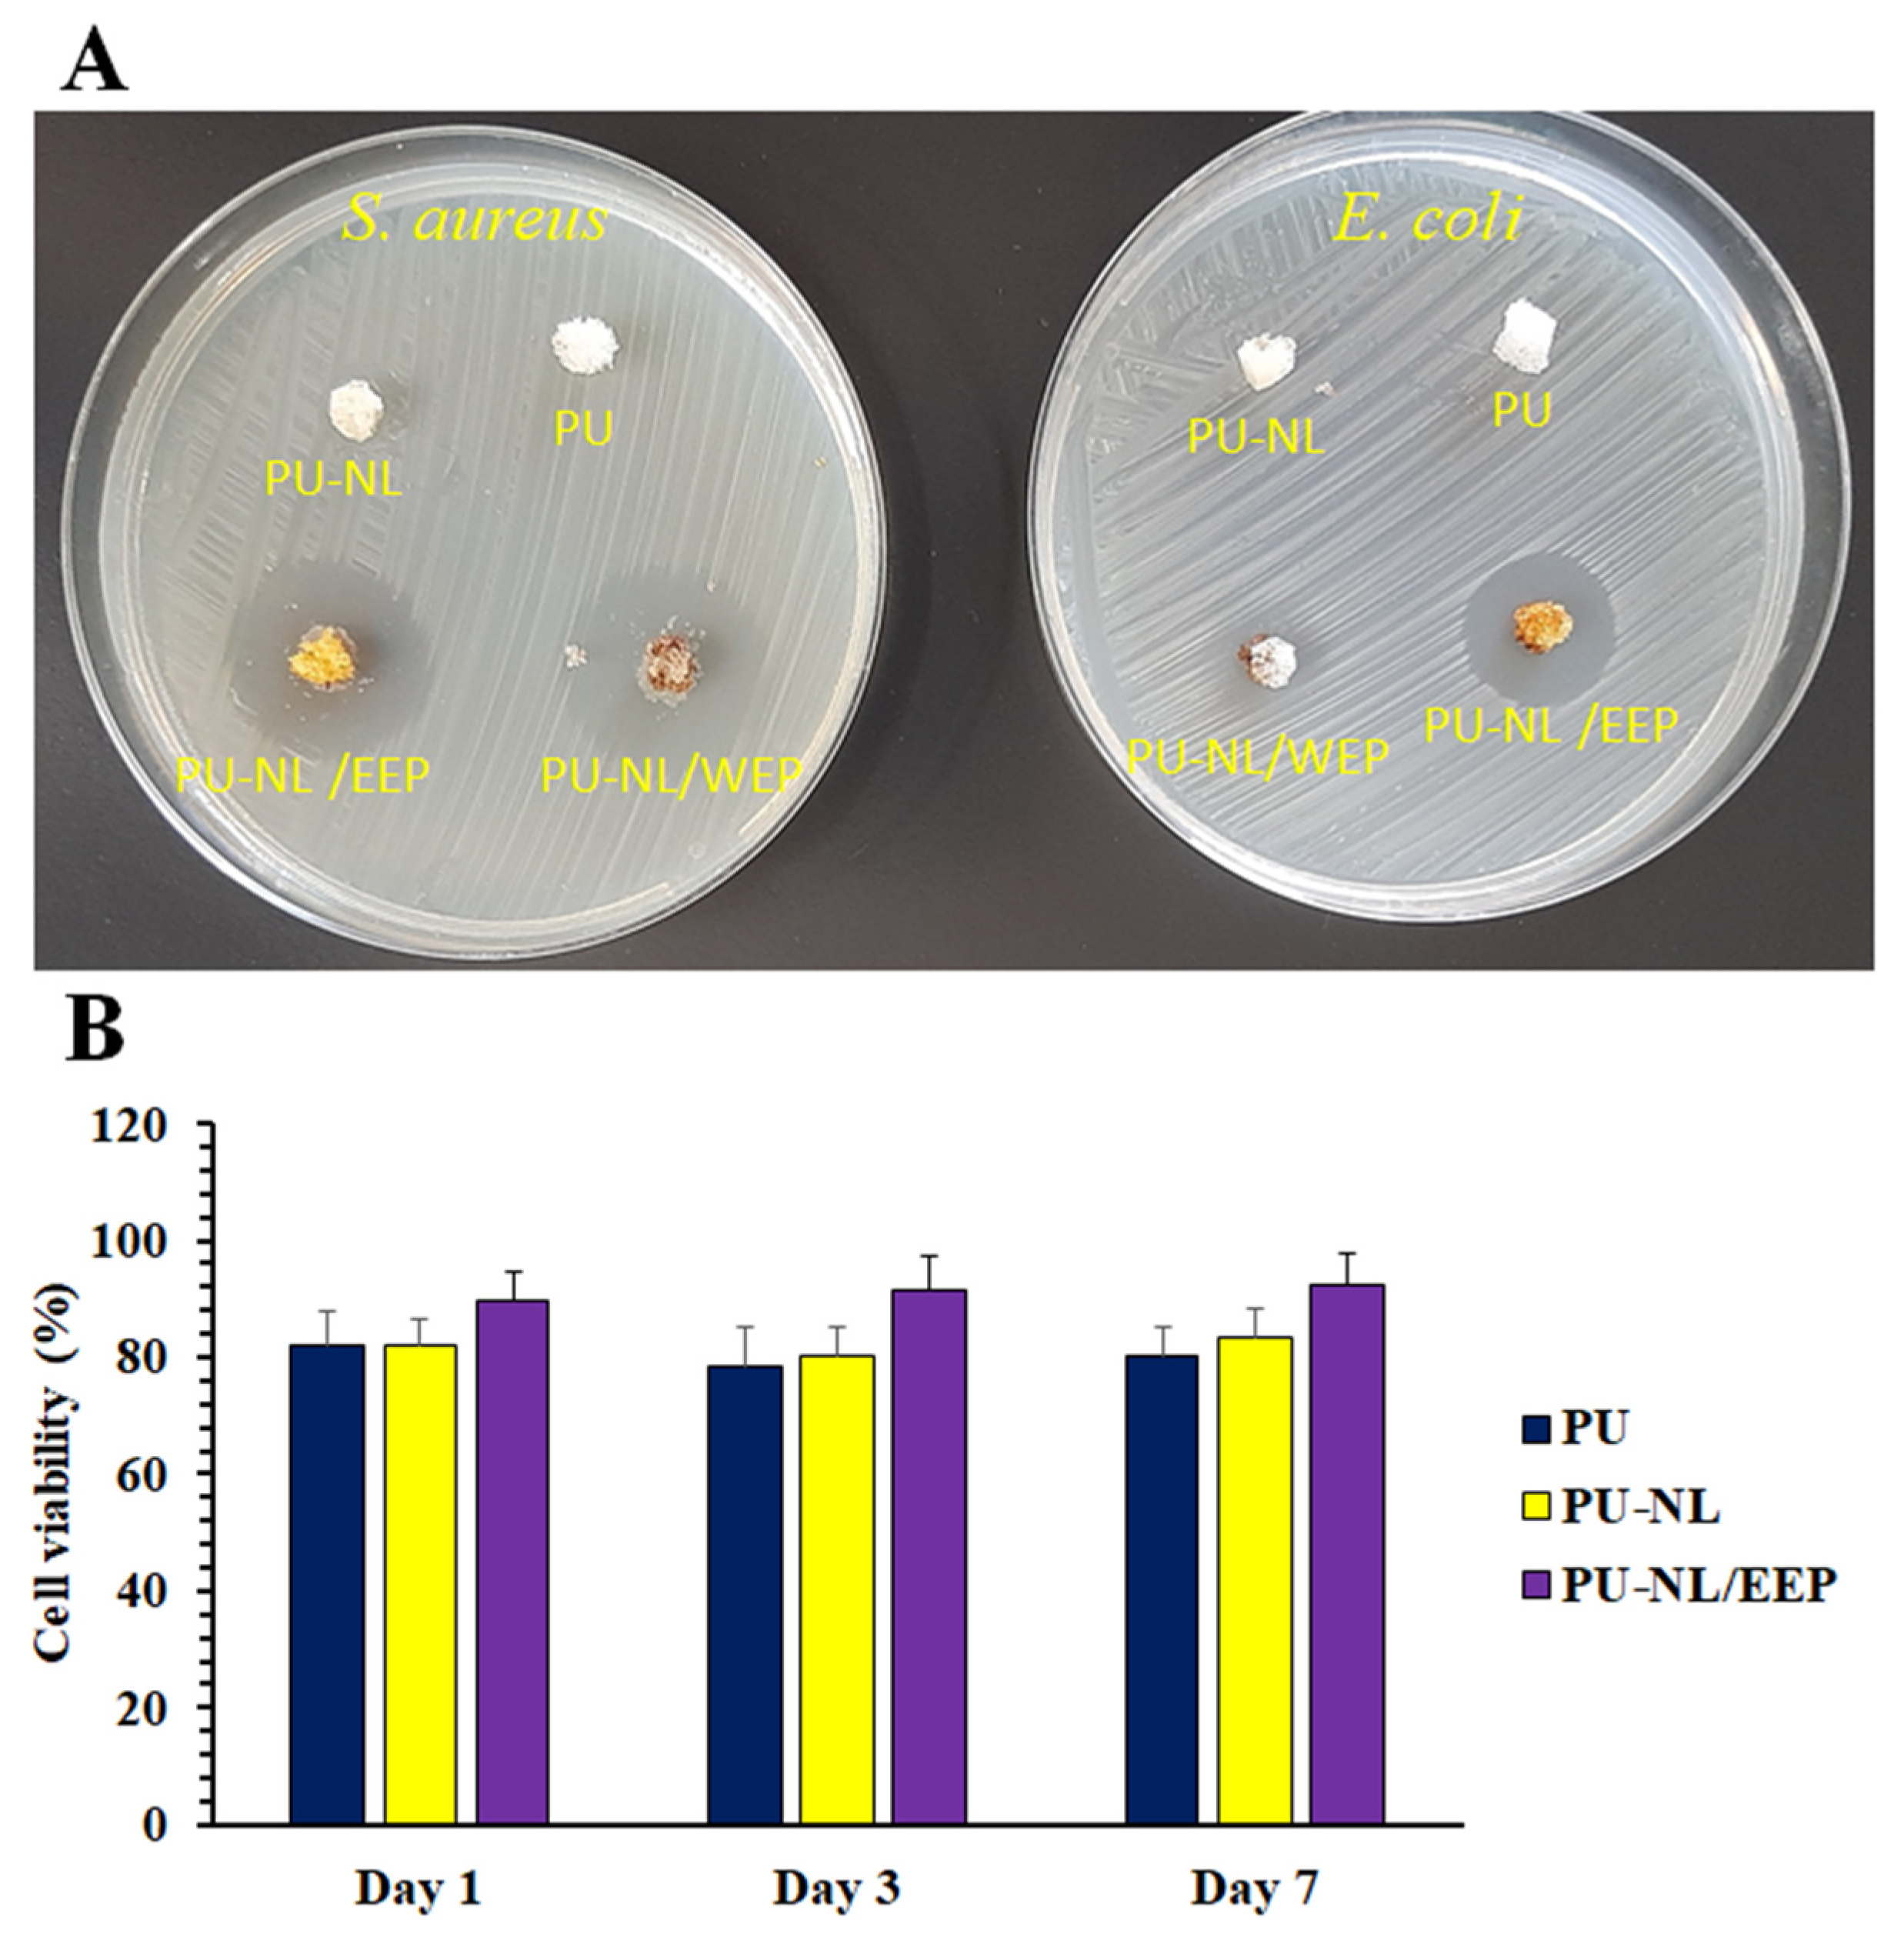
Polymers 13 03191 g005 550

Polyurethane-Nanolignin Composite Foam Coated with Propolis as a Platform for Wound Dressing: Synthesis and Characterization
Abstract
:1. Introduction
2. Materials and Methods
2.1. Materials
2.2. Methods
2.2.1. Synthesis of Polyurethane Foam Containing NL
2.2.2. Preparation of Propolis-Coated PU Foam Containing NL
2.2.3. Mechanical Properties
2.2.4. Fourier Transform Infrared Spectroscopy (FTIR)
2.2.5. Morphology and Density
2.2.6. Water Absorption Test of PU-NL and PU-NL/EEP Foams
2.2.7. Contact Angle Measurement
2.2.8. Particle Size Determination
2.2.9. Anti-Bacterial Test
2.2.10. Cell Viability Assay
2.2.11. Cell Adhesion
2.2.12. Animal Skin Wound Model and Histological Analyzes
2.2.13. Statistical Analysis
3. Results and Discussion
3.1. Dynamic Light Scattering (DLS)
3.2. Fourier-Transform Infrared Spectroscopy (FTIR) Analysis
3.3. Mechanical Properties
3.4. Morphological Characterization
3.5. Porosity and Density
3.6. Water Absorption Ability of PU-NL and PU-NL/EEP Foams
3.7. Contact Angle
3.8. Anti-Bacterial Activity
3.9. Cellular Biocompatibility
3.10. Fibroblast Adhesion to the PU-NL/EEP Wound Dressing
3.11. In Vivo Wound Healing Assessment
4. Conclusions
Author Contributions
Funding
Institutional Review Board Statement
Informed Consent Statement
Data Availability Statement
Conflicts of Interest
References
- Boateng, J.S.; Catanzano, O. Advanced therapeutic dressings for effective wound healing—A review. J. Pharm. Sci. 2015, 104, 3653–3680. [Google Scholar] [CrossRef] [Green Version]
- Nakielski, P.; Pawłowska, S.; Rinoldi, C.; Ziai, Y.; De Sio, L.; Urbanek, O.; Zembrzycki, K.; Pruchniewski, M.; Lanzi, M.; Salatelli, E.; et al. Multifunctional platform based on electrospun nanofibers and plasmonic hydrogel: A smart nanostructured pillow for near-infrared light-driven biomedical applications. ACS Appl. Mater. Interfaces 2020, 12, 54328–54342. [Google Scholar] [CrossRef]
- Mir, M.; Ali, M.N.; Barakullah, A.; Gulzar, A.; Arshad, M.; Fatima, S.; Asad, M. Synthetic polymeric biomaterials for wound healing: A review. Prog. Biomater. 2018, 7, 1–21. [Google Scholar] [CrossRef] [Green Version]
- Ozkaynak, M.U.; Atalay-Oral, C.; Tantekin-Ersolmaz, S.B.; Güner, F.S. Polyurethane films for wound dressing applications. Macromol. Symp. 2005, 228, 177–184. [Google Scholar] [CrossRef]
- Tian, S.; Chen, Y.; Zhu, Y.; Fan, H. A fluorescent polyurethane with covalently cross-linked rhodamine derivatives. Polymers 2020, 12, 1989. [Google Scholar] [CrossRef] [PubMed]
- Vermette, P.; Griesser, H.J.; Laroche, G.; Guidoin, R. Biomedical Applications of Polyurethanes; Landes Bioscience: Georgetown, TX, USA, 2001. [Google Scholar]
- Neisiany, R.E.; Enayati, M.S.; Sajkiewicz, P.; Pahlevanneshan, Z.; Ramakrishna, S. Insight into the current directions in functionalized nanocomposite hydrogels. Front. Mater. 2020, 7, 25. [Google Scholar] [CrossRef] [Green Version]
- Pyun, D.G.; Choi, H.J.; Yoon, H.S.; Thambi, T.; Lee, D.S. Polyurethane foam containing rhEGF as a dressing material for healing diabetic wounds: Synthesis, characterization, in vitro and in vivo studies. Colloids Surf. B Biointerfaces 2015, 135, 699–706. [Google Scholar] [CrossRef] [PubMed]
- Song, E.-H.; Jeong, S.-H.; Park, J.-U.; Kim, S.; Kim, H.-E.; Song, J. Polyurethane-silica hybrid foams from a one-step foaming reaction, coupled with a sol-gel process, for enhanced wound healing. Mater. Sci. Eng. C 2017, 79, 866–874. [Google Scholar] [CrossRef]
- Sahraro, M.; Yeganeh, H.; Sorayya, M. Guanidine hydrochloride embedded polyurethanes as antimicrobial and absorptive wound dressing membranes with promising cytocompatibility. Mater. Sci. Eng. C 2016, 59, 1025–1037. [Google Scholar] [CrossRef]
- Enayati, M.; Famili, M.H.N.; Janani, H. Open-celled microcellular foaming and the formation of cellular structure by a theoretical pattern in polystyrene. Iran. Polym. J. 2013, 22, 417–428. [Google Scholar] [CrossRef]
- Liu, X.; Niu, Y.; Chen, K.C.; Chen, S. Rapid hemostatic and mild polyurethane-urea foam wound dressing for promoting wound healing. Mater. Sci. Eng. C 2017, 71, 289–297. [Google Scholar] [CrossRef]
- Hu, J.; Tan, L. Polyurethane composites and nanocomposites for biomedical applications. In Polyurethane Polymers; Elsevier: Amsterdam, The Netherlands, 2017; pp. 477–498. [Google Scholar] [CrossRef]
- Chen, H. Chemical composition and structure of natural lignocellulose. In Biotechnology of Lignocellulose; Springer: Dordrecht, The Netherlands, 2014; pp. 25–71. [Google Scholar] [CrossRef]
- Domínguez-Robles, J.; Cárcamo-Martínez, Á.; Stewart, S.A.; Donnelly, R.F.; Larrañeta, E.; Borrega, M. Lignin for pharma-ceutical and biomedical applications–Could this become a reality? Sustain. Chem. Pharm. 2020, 18, 100320. [Google Scholar] [CrossRef]
- Rinoldi, C.; Zargarian, S.S.; Nakielski, P.; Li, X.; Liguori, A.; Petronella, F.; Presutti, D.; Wang, Q.; Costantini, M.; De Sio, L.; et al. Nanotechnology-assisted RNA delivery: From nucleic acid therapeutics to COVID-19 vaccines. Small Methods 2021, 5, 2100402. [Google Scholar] [CrossRef] [PubMed]
- Schneider, W.D.H.; Dillon, A.J.P.; Camassola, M. Lignin nanoparticles enter the scene: A promising versatile green tool for multiple applications. Biotechnol. Adv. 2020, 47, 107685. [Google Scholar] [CrossRef] [PubMed]
- Liu, R.; Dai, L.; Xu, C.; Wang, K.; Zheng, C.; Si, C. Lignin-based micro- and nanomaterials and their composites in biomedical applications. ChemSusChem 2020, 13, 4266–4283. [Google Scholar] [CrossRef] [PubMed]
- Reesi, F.; Minaiyan, M.; Taheri, A. A novel lignin-based nanofibrous dressing containing arginine for wound-healing applications. Drug Deliv. Transl. Res. 2018, 8, 111–122. [Google Scholar] [CrossRef]
- Kolakovic, R.; Peltonen, L.; Laukkanen, A.; Hirvonen, J.; Laaksonen, T. Nanofibrillar cellulose films for controlled drug delivery. Eur. J. Pharm. Biopharm. 2012, 82, 308–315. [Google Scholar] [CrossRef] [PubMed]
- Maillard, D.; Osso, E.; Faye, A.; Li, H.; Ton-That, M.T.; Stoeffler, K. Influence of lignin′s pH on polyurethane flexible foam formation and how to control it. J. Appl. Polym. Sci. 2021, 138, 50319. [Google Scholar] [CrossRef]
- Li, J.; Wang, B.; Chen, K.; Tian, X.; Zeng, J.; Xu, J.; Gao, W. The use of lignin as cross-linker for polyurethane foam for potential application in adsorbing materials. BioResources 2017, 12, 8653–8671. [Google Scholar] [CrossRef]
- Qi, G.; Yang, W.; Puglia, D.; Wang, H.; Xu, P.; Dong, W.; Zheng, T.; Ma, P. Hydrophobic, UV resistant and dielectric polyurethane-nanolignin composites with good reprocessability. Mater. Des. 2020, 196, 109150. [Google Scholar] [CrossRef]
- González, M.G.; Levi, M.; Turri, S.; Griffini, G. Lignin nanoparticles by ultrasonication and their incorporation in waterborne polymer nanocomposites. J. Appl. Polym. Sci. 2017, 134, 45318. [Google Scholar] [CrossRef]
- Oveissi, F.; Naficy, S.; Le, T.Y.L.; Fletcher, D.F.; Dehghani, F. Tough and processable hydrogels based on lignin and hydrophilic polyurethane. ACS Appl. Bio Mater. 2018, 1, 2073–2081. [Google Scholar] [CrossRef]
- Morena, A.G.; Stefanov, I.; Ivanova, K.; Pérez-Rafael, S.; Sánchez-Soto, M.; Tzanov, T. Antibacterial polyurethane foams with incorporated lignin-capped silver nanoparticles for chronic wound treatment. Ind. Eng. Chem. Res. 2020, 59, 4504–4514. [Google Scholar] [CrossRef]
- Simões, D.; Miguel, S.A.P.; Ribeiro, M.; Coutinho, P.; Mendonça, A.; Correia, I.J. Recent advances on antimicrobial wound dressing: A review. Eur. J. Pharm. Biopharm. 2018, 127, 130–141. [Google Scholar] [CrossRef] [PubMed]
- Oryan, A.; Alemzadeh, E.; Moshiri, A. Potential role of propolis in wound healing: Biological properties and therapeutic activities. Biomed. Pharmacother. 2018, 98, 469–483. [Google Scholar] [CrossRef] [PubMed]
- Mohammad, H.H. In vitro antibacterial activity of propolis, alum, miswak, green and black tea, cloves extracts against porphyromonas gingivalis isolated from periodontitis patients in Hilla City, Iraq. Am. J. Phytomed. Clin. Ther. 2013, 1, 140–148. [Google Scholar]
- Martinotti, S.; Ranzato, E. Propolis: A new frontier for wound healing? Burn. Trauma 2015, 3, 9. [Google Scholar] [CrossRef] [Green Version]
- Kim, D.-M.; Lee, G.-D.; Aum, S.-H.; Kim, H.-J. Preparation of propolis nanofood and application to human cancer. Biol. Pharm. Bull. 2008, 31, 1704–1710. [Google Scholar] [CrossRef] [Green Version]
- Kim, J.I.; Pant, H.R.; Sim, H.-J.; Lee, K.M.; Kim, C.S. Electrospun propolis/polyurethane composite nanofibers for biomedical applications. Mater. Sci. Eng. C 2014, 44, 52–57. [Google Scholar] [CrossRef]
- Khodabakhshi, D.; Eskandarinia, A.; Kefayat, A.; Rafienia, M.; Navid, S.; Karbasi, S.; Moshtaghian, J. In vitro and in vivo performance of a propolis-coated polyurethane wound dressing with high porosity and antibacterial efficacy. Colloids Surf. B Biointerfaces 2019, 178, 177–184. [Google Scholar] [CrossRef] [PubMed]
- Silva, R.P.D.; Machado, B.A.S.; Barreto, G.; Costa, S.S.; Andrade, L.N.; Amaral, R.G.; Carvalho, A.A.; Padilha, F.F.; Barbosa, J.D.V.; Umsza-Guez, M.A. Antioxidant, antimicrobial, antiparasitic, and cytotoxic properties of various Brazilian propolis extracts. PLoS ONE 2017, 12, e0172585. [Google Scholar] [CrossRef]
- Gilca, I.A.; Popa, V.I.; Crestini, C. Obtaining lignin nanoparticles by sonication. Ultrason. Sonochem. 2015, 23, 369–375. [Google Scholar] [CrossRef] [Green Version]
- Eskandarinia, A.; Kefayat, A.; Agheb, M.; Rafienia, M.; Baghbadorani, M.A.; Navid, S.; Ebrahimpour, K.; Khodabakhshi, D.; Ghahremani, F. A novel bilayer wound dressing composed of a dense polyurethane/propolis membrane and a biodegradable polycaprolactone/gelatin nanofibrous scaffold. Sci. Rep. 2020, 10, 3063. [Google Scholar] [CrossRef] [Green Version]
- Kalirajan, C.; Hameed, P.; Subbiah, N.; Palanisamy, T. A facile approach to fabricate dual purpose hybrid materials for tissue engineering and water remediation. Sci. Rep. 2019, 9, 1040. [Google Scholar] [CrossRef] [PubMed] [Green Version]
- Kefayat, A.; Ghahremani, F.; Motaghi, H.; Amouheidari, A. Ultra-small but ultra-effective: Folic acid-targeted gold nanoclusters for enhancement of intracranial glioma tumors′ radiation therapy efficacy. Nanomed. Nanotechnol. Biol. Med. 2018, 16, 173–184. [Google Scholar] [CrossRef]
- Ghahremani, F.; Shahbazi-Gahrouei, D.; Kefayat, A.; Motaghi, H.; Mehrgardi, M.A.; Javanmard, S.H. AS1411 aptamer conjugated gold nanoclusters as a targeted radiosensitizer for megavoltage radiation therapy of 4T1 breast cancer cells. RSC Adv. 2018, 8, 4249–4258. [Google Scholar] [CrossRef] [Green Version]
- Animal Research Advisory Committee. Guidelines for Endpoints in Animal Study Proposals. Available online: http://oacu.od.nih.gov/ARAC/documents/ASP_Endpoints.pdf (accessed on 20 September 2021).
- Committee of the National Cancer Research Institute; Workman, P.; Aboagye, E.; Balkwill, F.; Balmain, A.; Bruder, G.; Chaplin, D.J.; Double, J.A.; Everitt, J.; Farningham, D.A.H.; et al. Guidelines for the welfare and use of animals in cancer research. Br. J. Cancer 2010, 102, 1555–1577. [Google Scholar] [CrossRef] [PubMed] [Green Version]
- Wallace, J. Humane endpoints and cancer research. ILAR J. 2000, 41, 87–93. [Google Scholar] [CrossRef] [PubMed] [Green Version]
- Ibrahim, K.E.; Al-Mutary, M.G.; Bakhiet, A.O.; Khan, H.A. Histopathology of the liver, kidney, and spleen of mice exposed to gold nanoparticles. Molecules 2018, 23, 1848. [Google Scholar] [CrossRef] [Green Version]
- Wang, Y.-Y.; Wyman, C.E.; Cai, C.M.; Ragauskas, A.J. Lignin-based polyurethanes from unmodified kraft lignin fractionated by sequential precipitation. ACS Appl. Polym. Mater. 2019, 1, 1672–1679. [Google Scholar] [CrossRef] [Green Version]
- Da Silva, C.; Prasniewski, A.; Calegari, M.A.; De Lima, V.A.; Oldoni, T.L.C. Determination of total phenolic compounds and antioxidant activity of ethanolic extracts of propolis using ATR–FT-IR spectroscopy and chemometrics. Food Anal. Methods 2018, 11, 2013–2021. [Google Scholar] [CrossRef]
- Gomes, S.; Rodrigues, G.; Martins, G.; Roberto, M.; Mafra, M.; Henriques, C.; Silva, J. In vitro and in vivo evaluation of electrospun nanofibers of PCL, chitosan and gelatin: A comparative study. Mater. Sci. Eng. C 2014, 46, 348–358. [Google Scholar] [CrossRef]
- Negut, I.; Dorcioman, G.; Grumezescu, V. Scaffolds for wound healing applications. Polymers 2020, 12, 2010. [Google Scholar] [CrossRef] [PubMed]
- Gondaliya, A.; Nejad, M. Lignin as a partial polyol replacement in polyurethane flexible foam. Molecules 2021, 26, 2302. [Google Scholar] [CrossRef] [PubMed]
- Doillon, C.J. Porous Collagen Sponge Wound Dressings: In vivo and in vitro Studies. J. Biomater. Appl. 1987, 2, 562–578. [Google Scholar] [CrossRef] [PubMed]
- Wang, X.; Lou, T.; Zhao, W.; Song, G.; Li, C.; Cui, G. The effect of fiber size and pore size on cell proliferation and infiltration in PLLA scaffolds on bone tissue engineering. J. Biomater. Appl. 2016, 30, 1545–1551. [Google Scholar] [CrossRef]
- Lee, S.M.; Park, I.K.; Kim, Y.S.; Kim, H.J.; Moon, H.; Mueller, S.; Jeong, Y.-I. Physical, morphological, and wound healing properties of a polyurethane foam-film dressing. Biomater. Res. 2016, 20, 15. [Google Scholar] [CrossRef] [PubMed] [Green Version]
- Sin, D.; Miao, X.; Liu, G.; Wei, F.; Chadwick, G.; Yan, C.; Friis, T. Polyurethane (PU) scaffolds prepared by solvent cast-ing/particulate leaching (SCPL) combined with centrifugation. Mater. Sci. Eng. C 2010, 30, 78–85. [Google Scholar] [CrossRef] [Green Version]
- Shao, W.; Wu, J.; Wang, S.; Huang, M.; Liu, X.; Zhang, R. Construction of silver sulfadiazine loaded chitosan composite sponges as potential wound dressings. Carbohydr. Polym. 2016, 157, 1963–1970. [Google Scholar] [CrossRef]
- Sabbahi, A.; Vergnaud, J. Absorption of water by polyurethane foam. modelling and experiments. Eur. Polym. J. 1993, 29, 1243–1246. [Google Scholar] [CrossRef]
- Eskandarinia, A.; Kefayat, A.; Gharakhloo, M.; Agheb, M.; Khodabakhshi, D.; Khorshidi, M.; Sheikhmoradi, V.; Rafienia, M.; Salehi, H. A propolis enriched polyurethane-hyaluronic acid nanofibrous wound dressing with remarkable antibacterial and wound healing activities. Int. J. Biol. Macromol. 2020, 149, 467–476. [Google Scholar] [CrossRef]
- Eskandarinia, A.; Kefayat, A.; Rafienia, M.; Agheb, M.; Navid, S.; Ebrahimpour, K. Cornstarch-based wound dressing in-corporated with hyaluronic acid and propolis: In vitro and in vivo studies. Carbohydr. Polym. 2019, 216, 25–35. [Google Scholar] [CrossRef]
- Santos, O.; da Silva, M.C.; Silva, V.; Mussel, W.; Yoshida, M. Polyurethane foam impregnated with lignin as a filler for the removal of crude oil from contaminated water. J. Hazard. Mater. 2017, 324, 406–413. [Google Scholar] [CrossRef]
- Bessa, L.; Fazii, P.; Di Giulio, M.; Cellini, L. Bacterial isolates from infected wounds and their antibiotic susceptibility pattern: Some remarks about wound infection. Int. Wound J. 2013, 12, 47–52. [Google Scholar] [CrossRef]
- Pobiega, K.; Kraśniewska, K.; Derewiaka, D.; Gniewosz, M. Comparison of the antimicrobial activity of propolis extracts obtained by means of various extraction methods. J. Food Sci. Technol. 2019, 56, 5386–5395. [Google Scholar] [CrossRef] [PubMed] [Green Version]
- Liaudanskas, M.; Kubilienė, L.; Žvikas, V.; Trumbeckaitė, S. Comparison of Ethanolic and aqueous-polyethylenglycolic propolis extracts: Chemical composition and antioxidant properties. Evid.-Based Complement. Altern. Med. 2021, 2021, 5557667. [Google Scholar] [CrossRef]
- Hsouna, A.B.; Trigui, M.; Mansour, R.B.; Jarraya, R.M.; Damak, M.; Jaoua, S. Chemical composition, cytotoxicity effect and antimicrobial activity of Ceratonia siliqua essential oil with preservative effects against Listeria inoculated in minced beef meat. Int. J. Food. Microbiol. 2011, 148, 66–72. [Google Scholar] [CrossRef] [PubMed]
- Archana, D.; Singh, B.K.; Dutta, J.; Dutta, P. Chitosan-PVP-nano silver oxide wound dressing: In vitro and in vivo evaluation. Int. J. Biol. Macromol. 2015, 73, 49–57. [Google Scholar] [CrossRef] [PubMed]
- Xu, C.-A.; Chen, G.; Tan, Z.; Hu, Z.; Qu, Z.; Zhang, Q.; Lu, M.; Wu, K.; Lu, M.; Liang, L. Evaluation of cytotoxicity in vitro and properties of polysiloxane-based polyurethane/lignin elastomers. React. Funct. Polym. 2020, 149, 104514. [Google Scholar] [CrossRef]
- Popova, M.; Giannopoulou, E.; Skalicka-Woźniak, K.; Graikou, K.; Widelski, J.; Bankova, V.; Kalofonos, H.; Sivolapenko, G.; Gaweł-Bęben, K.; Antosiewicz, B.; et al. Characterization and biological evaluation of propolis from Poland. Molecules 2017, 22, 1159. [Google Scholar] [CrossRef]
- Khabbaz, B.; Solouk, A.; Mirzadeh, H. Polyvinyl alcohol/soy protein isolate nanofibrous patch for wound-healing applications. Prog. Biomater. 2019, 8, 185–196. [Google Scholar] [CrossRef] [PubMed] [Green Version]

| Sample | Elongation at Break (%) | Tensile Strength (MPa) | Tensile Modulus (MPa) |
|---|---|---|---|
| PU | 91 ± 3.5 | 0.75 ± 0.08 | 0.95 ± 0.15 |
| PU-NL | 96 ± 5.6 | 0.91 ± 0.1 | 1.25 ± 0.45 |
| PU-NL/EEP | 73 ± 3.9 | 0.82 ± 0.09 | 0.84 ± 0.19 |
| Microorganism | PU | PU-NL | PU-NL/WEP | PU-NL/EEP |
|---|---|---|---|---|
| E. coli | 0 | 0 | 4.3 ± 0.3 | 7.2 ± 0.4 |
| S. aureus | 0 | 2.1 ± 0.3 | 10.5 ± 0.7 | 11.2 ± 0.6 |
Publisher’s Note: MDPI stays neutral with regard to jurisdictional claims in published maps and institutional affiliations. |
© 2021 by the authors. Licensee MDPI, Basel, Switzerland. This article is an open access article distributed under the terms and conditions of the Creative Commons Attribution (CC BY) license (https://creativecommons.org/licenses/by/4.0/).
Share and Cite
Pahlevanneshan, Z.; Deypour, M.; Kefayat, A.; Rafienia, M.; Sajkiewicz, P.; Esmaeely Neisiany, R.; Enayati, M.S. Polyurethane-Nanolignin Composite Foam Coated with Propolis as a Platform for Wound Dressing: Synthesis and Characterization. Polymers 2021, 13, 3191. https://doi.org/10.3390/polym13183191
Pahlevanneshan Z, Deypour M, Kefayat A, Rafienia M, Sajkiewicz P, Esmaeely Neisiany R, Enayati MS. Polyurethane-Nanolignin Composite Foam Coated with Propolis as a Platform for Wound Dressing: Synthesis and Characterization. Polymers. 2021; 13(18):3191. https://doi.org/10.3390/polym13183191
Chicago/Turabian StylePahlevanneshan, Zari, Mohammadreza Deypour, Amirhosein Kefayat, Mohammad Rafienia, Paweł Sajkiewicz, Rasoul Esmaeely Neisiany, and Mohammad Saeid Enayati. 2021. "Polyurethane-Nanolignin Composite Foam Coated with Propolis as a Platform for Wound Dressing: Synthesis and Characterization" Polymers 13, no. 18: 3191. https://doi.org/10.3390/polym13183191
APA StylePahlevanneshan, Z., Deypour, M., Kefayat, A., Rafienia, M., Sajkiewicz, P., Esmaeely Neisiany, R., & Enayati, M. S. (2021). Polyurethane-Nanolignin Composite Foam Coated with Propolis as a Platform for Wound Dressing: Synthesis and Characterization. Polymers, 13(18), 3191. https://doi.org/10.3390/polym13183191

